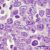
Genomic Testing Cooperative

Acute Lymphoblastic Leukemia Genomic Testing Cooperative

Acute Myeloid Leukemia Ash Annual Meeting Abstract Genomic Testing Acute lymphoblastic leukemia (all) is a heterogeneous disease with genomic alterations dominated by structural chromosomal abnormalities, particularly translocations. Genomic fusion breakpoints for dna based measurable residual disease monitoring in pediatric acute lymphoblastic leukemia arno h. houtman, chloé arfeuille, marion strullu, andré baruchel,.

Acute Lymphoblastic Leukemia Genomic Testing Cooperative In this review we describe these approaches and highlight the extensive heterogeneity that underpins all gene expression, cellular differentiation, and clonal architecture throughout disease pathogenesis and treatment resistance. Acute myeloid leukemia: clinical studies: poster i molecular epidemiologic associations in acute myeloid leukemia (aml) and myelodysplastic syndromes (mds) within the united states. Acute lymphoblastic leukemia (all) is a heterogenous disease with genomic alterations dominated by structural chromosomal abnormalities, particularly translocations. Recommendations for the assessment and management of measurable residual disease in adults with acute lymphoblastic leukemia: a consensus of north american experts the vast majority of.

Acute Lymphoblastic Leukemia A Consensus Of North American Experts Acute lymphoblastic leukemia (all) is a heterogenous disease with genomic alterations dominated by structural chromosomal abnormalities, particularly translocations. Recommendations for the assessment and management of measurable residual disease in adults with acute lymphoblastic leukemia: a consensus of north american experts the vast majority of. Therefore, the aim of this review is to compare, summarize, and highlight some of the recent findings in acute lymphoblastic leukemia based on ngs applications. keywords: acute lymphoblastic leukemia, next generation sequencing (ngs), whole genome sequencing, personalized medicine. The target acute lymphoblastic leukemia projects uses comprehensive molecular characterization to determine the genetic changes that drive the initiation and progression of hard to treat childhood cancers. Measurable residual disease (mrd) is the most powerful predictor of relapse and long term survival in adult acute lymphoblastic leukemia (all), consistently outperforming traditional clinical and cytogenetic risk factors. the advent of high sensitivity next generation sequencing (ngs) capable of detecting mrd at 10−6 has transformed monitoring, reclassifying a substantial proportion of. This test includes dna and rna sequencing and provides complete evaluation and classification of dlbcl. it will help distinguish abc from gcb, determine double hit lymphoma, rule out burkitt as well as angioimmunoblastic lymphoma, and provide future monitoring of minimal residual disease and relapse.
Genomic Testing Cooperative Therefore, the aim of this review is to compare, summarize, and highlight some of the recent findings in acute lymphoblastic leukemia based on ngs applications. keywords: acute lymphoblastic leukemia, next generation sequencing (ngs), whole genome sequencing, personalized medicine. The target acute lymphoblastic leukemia projects uses comprehensive molecular characterization to determine the genetic changes that drive the initiation and progression of hard to treat childhood cancers. Measurable residual disease (mrd) is the most powerful predictor of relapse and long term survival in adult acute lymphoblastic leukemia (all), consistently outperforming traditional clinical and cytogenetic risk factors. the advent of high sensitivity next generation sequencing (ngs) capable of detecting mrd at 10−6 has transformed monitoring, reclassifying a substantial proportion of. This test includes dna and rna sequencing and provides complete evaluation and classification of dlbcl. it will help distinguish abc from gcb, determine double hit lymphoma, rule out burkitt as well as angioimmunoblastic lymphoma, and provide future monitoring of minimal residual disease and relapse.

Brochures Genomic Testing Cooperative Measurable residual disease (mrd) is the most powerful predictor of relapse and long term survival in adult acute lymphoblastic leukemia (all), consistently outperforming traditional clinical and cytogenetic risk factors. the advent of high sensitivity next generation sequencing (ngs) capable of detecting mrd at 10−6 has transformed monitoring, reclassifying a substantial proportion of. This test includes dna and rna sequencing and provides complete evaluation and classification of dlbcl. it will help distinguish abc from gcb, determine double hit lymphoma, rule out burkitt as well as angioimmunoblastic lymphoma, and provide future monitoring of minimal residual disease and relapse.
Comments are closed.